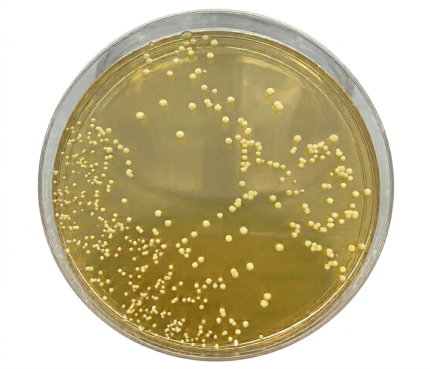
MANNITOL SALT AGAR

- Wishlist
- SKU : 4016652
- 500 g
Additional Info
| Brand |
BioLife |
|---|
In vitro diagnostic device. Selective medium for the isolation and differentiation of staphylococci from clinical and non clinical specimens.
Be the first to review “MANNITOL SALT AGAR” Cancel reply
You must be logged in to post a review.

Reviews
There are no reviews yet.